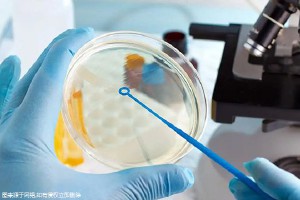

今年襄陽(yáng)的第三代試管嬰兒費(fèi)用是多少呢?許多備孕家庭都對(duì)這個(gè)城市做第三代試管嬰兒充滿(mǎn)好奇。作為一座歷史文化名城,襄陽(yáng)在醫(yī)療技術(shù)方面也日新月異,為想要生孩子的家庭提供了更多選擇。為了幫助大家更好地了解襄陽(yáng)第三代試管嬰兒的相關(guān)信息,本文將從費(fèi)用明細(xì)、助孕成功率等方面進(jìn)行詳細(xì)介紹,希望能夠解答大家的疑問(wèn)。

襄陽(yáng)第三代試管嬰兒費(fèi)用明細(xì)
襄陽(yáng)做第三代試管嬰兒的總費(fèi)用一般在8-12萬(wàn)左右,具體費(fèi)用根據(jù)個(gè)人的情況會(huì)有所差異。不同的醫(yī)院、不同的方案以及個(gè)人體質(zhì)都會(huì)影響最終的費(fèi)用支出。 以下是一些常見(jiàn)的費(fèi)用項(xiàng)目:
- 檢查費(fèi)用: 包括卵巢超聲檢查、激素水平檢測(cè)、染色體異常篩查等,大約需要幾千元。
- 促排卵藥物費(fèi)用: 根據(jù)個(gè)人的情況選擇不同種類(lèi)的促排卵藥物,費(fèi)用大約在萬(wàn)元左右。
- 促排卵和胚胎培養(yǎng)費(fèi)用: 促排卵手術(shù)和胚胎培養(yǎng)過(guò)程的費(fèi)用大約在1萬(wàn)-2萬(wàn)元左右。
- PGD基因篩查費(fèi)用: 對(duì)胚胎進(jìn)行PGD基因篩查,能夠篩選出健康優(yōu)質(zhì)胚胎,費(fèi)用大約在5000元左右。
- 胚胎移植費(fèi)用: 將健康的胚胎移植到女性子宮內(nèi),費(fèi)用大約在幾千元。
- 其他輔助治療費(fèi)用: 例如保胎藥物、輸血等,具體費(fèi)用根據(jù)情況而定。
襄陽(yáng)第三代試管嬰兒成功率參考
襄陽(yáng)市內(nèi)的各大醫(yī)院均擁有專(zhuān)業(yè)的生殖醫(yī)學(xué)團(tuán)隊(duì)和先進(jìn)的醫(yī)療設(shè)備,第三代試管嬰兒技術(shù)水平較高。 隨著技術(shù)的不斷進(jìn)步,第三代試管嬰兒的成功率也逐漸提高,一般在40%-75%之間。具體成功率還受很多因素影響,比如女性年齡、身體狀況、胚胎質(zhì)量等。
襄陽(yáng)市熱門(mén)助孕醫(yī)院
襄陽(yáng)市擁有多家實(shí)力雄厚的生育醫(yī)療機(jī)構(gòu),為備孕家庭提供高質(zhì)量的生殖輔助服務(wù)。以下是部分熱門(mén)助孕醫(yī)院:
襄陽(yáng)市生育保健院
襄陽(yáng)市生育保健院是集臨床診治、科研教學(xué)、康復(fù)護(hù)理等功能于一體的綜合性醫(yī)院,擁有專(zhuān)業(yè)的生殖醫(yī)學(xué)團(tuán)隊(duì)和先進(jìn)的技術(shù)設(shè)備。該院開(kāi)展了第三代試管嬰兒等多種生殖輔助技術(shù),成功率較高,深受廣大患者好評(píng)。
襄陽(yáng)市重點(diǎn)醫(yī)院
襄陽(yáng)市重點(diǎn)醫(yī)院是一家集醫(yī)療、教學(xué)、科研為一體的綜合性大型醫(yī)院,擁有豐富的臨床經(jīng)驗(yàn)和先進(jìn)的技術(shù)設(shè)備。該院生殖醫(yī)院致力于為備孕家庭提供優(yōu)質(zhì)的生育輔助服務(wù),開(kāi)展了第三代試管嬰兒等多種技術(shù),成功率較高。
總而言之,襄陽(yáng)作為一座歷史文化名城,近年來(lái)在醫(yī)療技術(shù)方面發(fā)展迅速,特別是第三代試管嬰兒技術(shù)的應(yīng)用,為想要生孩子的家庭提供了更多的選擇。根據(jù)個(gè)人需求和情況,選擇合適的醫(yī)院和方案進(jìn)行治療,才能提高成功率,實(shí)現(xiàn)孕育美滿(mǎn)的愿望。
任何關(guān)于疾病的建議都不能替代執(zhí)業(yè)醫(yī)師的面對(duì)面診斷,請(qǐng)謹(jǐn)慎參閱。本站不承擔(dān)由此引起的法律責(zé)任
免責(zé)聲明:本站上所有內(nèi)容均出于傳遞更多信息之目的,并不意味著贊同其觀(guān)點(diǎn)或證實(shí)其描述。